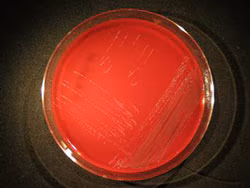
Capnocytophaga species are fastidious, slow-growing, Gram-negative bacteria.

What to know
Capnocytophaga is a rare infection usually caused by bacteria from dog or cat bites. Symptoms start 3-5 days after exposure and can progress from mild, localized infection to a dangerous systemic infection. Capnocytophaga infections can be treated with antibiotics, but disease complications can arise quickly and potentially be fatal.

Signs and symptoms
There are 9 species of Capnocytophaga, which can be classified into 2 main categories:
Human-oral associated, seen more commonly in immunocompromised patients: C. gingivalis, C. granulosa, C. haemolytica, C. leadbetteri, C. ochracea, and C. Sputigena
Most reported human-oral associated Capnocytophaga infections cause:
- Periodontal infections
- Respiratory tract infections
- Ocular infections
Zoonosis associated, seen more commonly in asplenic patients or those with liver disease: C. canimorsus, C. canis, and C. cynodegmi
Symptoms from zoonosis associated Capnocytophaga infections typically begin about 3 to 5 days after a dog or cat bite. The disease can progress rapidly from mild, localized infection to systemic infection, sepsis, and death.
Signs and symptoms of a Capnocytophaga infection include:
- Blisters at the bite or scratch wound
- Redness, swelling, draining pus, or pain at the wound
- Fever
- Diarrhea and/or stomach pain
- Vomiting
- Headache and/or confusion
Risk factors
Most Capnocytophaga infections occur in adults over 40 years of age.
People with the following medical histories comprise 60% of Capnocytophaga infections:
- Splenectomies
- Excessive alcohol use (regular binge or heavy drinking)
- Cancer and cancer treatment
- Chronic lung disease
- Diabetes
Trends
Capnocytophaga infections are not nationally notifiable, and therefore there is no national estimate of incidence. Cases are rarely reported in the literature.
Laboratory testing and identification
Capnocytophaga species are slow-growing, Gram-negative bacteria that are difficult to grow in a laboratory setting.
Blood samples are usually used to identify the bacteria in culture, but identification can be difficult. In a California study, only approximately 1/3 of Capnocytophaga samples were correctly identified by the state public health laboratories that submitted them.
Automated blood culture systems may not identify Capnocytophaga growth because of its slow-growing nature. Some other bacteria species are very similar to Capnocytophaga, and biochemical analysis used to identify bacteria species may not be able to tell the difference.
Other more reliable methods for identifying Capnocytophaga include:
- PCR
- 16S rRNA gene amplification
- Matrix Assisted Laser Desorption/Ionization Time of Flight (MALDI TOF) mass spectrometry
CDC's Special Bacteriology Reference Laboratory or your state health department laboratory can conduct these tests. To submit a sample to CDC for Capnocytophaga identification, see laboratory submission information.
All submissions to CDC must come from within the United States and must be approved by your state health department.
MicrobeNet, a CDC virtual reference laboratory, can also help identify rare pathogens like Capnocytophaga.
Treatment and recovery
Capnocytophaga is typically sensitive to routinely used antibiotics. Healthcare providers can determine the most appropriate course of treatment based on patient's history and clinical presentation.
Patients with severe Capnocytophaga infection should be treated initially with a beta-lactam-beta-lactamase combination (such as piperacillin-tazobactam) or a carbapenem (such as imipenem), pending susceptibility testing. If antibiotic susceptibilities are performed, the regimen can be adjusted accordingly. Patients with non-severe infection may be treated with oral therapy such as amoxicillin-clavulanate or clindamycin.
The infection can quickly progress, and death is due to complications from shock, disseminated intravascular coagulation (DIC), and organ failure. Capnocytophaga-associated morbidity can include sepsis, myocardial infarction, renal failure, and amputation because of DIC.
Asplenic patients have a 30 to 60 times greater risk of death from Capnocytophaga infections. These patients can advance to organ failure and death within 24 to 72 hours of onset.
- Janda JM, Graves MH, Lindquist D, Probert WS. Diagnosing Capnocytophaga canimorsus infections. Emerg Infect Dis. 2006 Feb;12(2):340-2.Capnocytophaga canimorsus Sepsis Misdiagnosed as Plague—New Mexico, 1992. MMWR 1993 42(04);72-73.
- Dupin C, Tamanai-Shacoori Z, Ehrmann E, Dupont A, Barloy-Hubler F, Bousarghin L, Bonnaure-Mallet M, Jolivet-Gougeon A. Oral Gram-negative anaerobic bacilli as a reservoir of β-lactam resistance genes facilitating infections with multiresistant bacteria. Int J Antimicrob Agents. 2015 Feb;45(2):99-105.
- Gaastra W, Lipman LJ. Capnocytophaga canimorsus. Vet Microbiol. 2010 Jan 27;140(3-4):339-46.
- Gasch O, Fernández N, Armisen A, Verdaguer R, Fernández P. Community-acquired Capnocytophaga canimorsus meningitis in adults: report of one case with a subacute course and deafness, and literature review. Enferm Infecc Microbiol Clin. 2009 Jan;27(1):33-6.
- Hloch O, Mokra D, Masopust J, Hasa J, Charvat J. Antibiotic treatment following a dog bite in an immunocompromized patient in order to prevent Capnocytophaga canimorsus infection: a case report. BMC Res Notes. 2014 Jul 5;7:432. doi: 10.1186/1756-0500-7-432.
- Jolivet-Gougeon A, Sixou JL, Tamanai-Shacoori Z, Bonnaure-Mallet M. Antimicrobial treatment of Capnocytophaga infections. Int J Antimicrob Agents. 2007 Apr;29(4):367-73.
- Lopez E, Raymond J, Patkai J, El Ayoubi M, Schmitz T, Moriette G, Jarreau PH. Capnocytophaga species and preterm birth: case series and review of the literature. Clin Microbiol Infect. 2010 Oct;16(10):1539-43.
- Mekouar H, Voortman G, Bernard P, Hutchings G, Boeras A, Rodriguez-Villalobos H. Capnocytophaga species and perinatal infections: case report and review of the literature. Acta Clin Belg. 2012 Jan-Feb;67(1):42-5.
- Oehler RL, Velez AP, Mizrachi M, Lamarche J, Gompf S. Bite-related and septic syndromes caused by cats and dogs. Lancet Infect Dis. 2009 Jul;9(7):439-47.
- Piau C, Arvieux C, Bonnaure-Mallet M, Jolivet-Gougeon A. Capnocytophaga spp. involvement in bone infections: a review. Int J Antimicrob Agents. 2013 Jun;41(6):509-15.
- Sabbatani S, Manfredi R, Frank G, Chiodo F. Capnocytophaga spp. brain abscess in an immunocompetent host: problems in antimicrobial chemotherapy and literature review. J Chemother. 2004 Oct;16(5):497-501.
- Popiel KY, Vinh DC. 'Bobo-Newton syndrome': An unwanted gift from man's best friend. Can J Infect Dis Med Microbiol. 2013 Winter;24(4):209-14.
- Ugai T, Sugihara H, Nishida Y, Yamakura M, Takeuchi M, Matsue K. Capnocytophaga canimorsus sepsis following BMT in a patient with AML: possible association with functional asplenia. Bone Marrow Transplant. 2014 Jan;49(1):153-4.